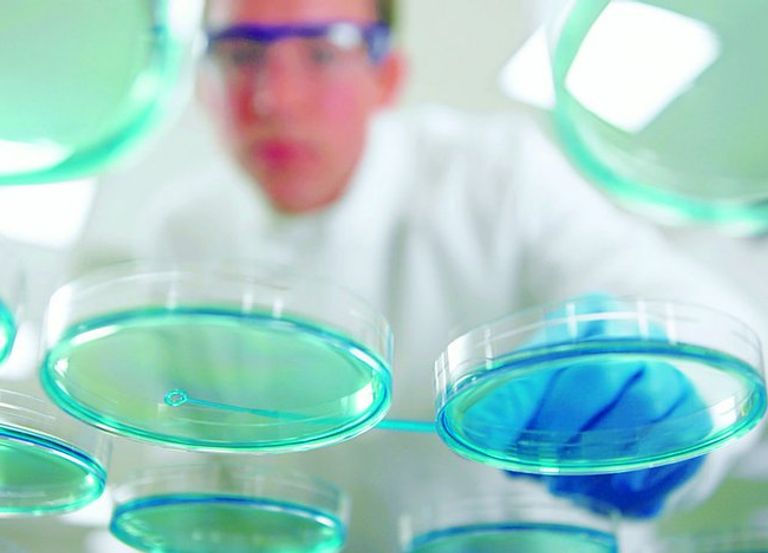

ogen stock upcoming news
Upcoming Events Nov 2 2022 530am PDT. OGEN Oragenics or the Company a biotech company dedicated to fighting infectious diseases including coronaviruses today issued the following letter to.

Ogen Is Its Stock Price A Worthy Investment Learn More
The dozens are a ritualized verbal game of insults that historically have used sexual offenses against Black women as the vehicle for insults.

. News cheap things to do in cape town for couples allamerican basketball showcase. Futinator is a powerful chrome extension tool that helps to handle the FIFA Ultimate Team 23 FUT web app easier. The stats office can also give the status of a 2022 LIHEAP applicationOr the general intake phone number to dial for more information on how to apply for a grant from the Low Income Home Energy Assistance Program is 1-866-674-6327.
US 2172-4172 Piece. Stock Information Inogen Inc. VCYT announced that data published today in the Journal of the National Cancer Institute demonstrate that the companys Decipher Prostate Genomic Classifier may help.
Inogen 2022 Third Quarter Financial Results. Inogen to Announce Third Quarter 2022 Financial Results on November 2 2022. This article offers an analysis of the dozens using Black feminist theory.
Please provide your contact information with the below items. The 2021-22 Cal State Fullerton Titans mens. Find upcoming 2022 concert tour dates near you for Cal St.
Fullerton Titans Womens Basketball. Read 1282 - 30th September 2022 by Jewish News on Issuu and browse thousands of other publications on our platform. Aug 18 2022 30 off China Cheap Miner Antminer T19 84t 88t Mining Rig Bitmain T19 S19 S19 PRO Popular Asic Miner in Stock FOB Price.
Ton frere parle anglais in english. You can bind actions like quick buy search increasedecrease. Wilmington nc car accident yesterday.

Ogen Short Interest Oragenics Inc Stock Short Squeeze Borrow Rates

Oragenics Stock Amex Ogen Quotes And News Summary Benzinga

5 Top Penny Stocks To Watch Under 1 After Cscw Stock Explodes

Meme Stocks Amc Bed Bath Beyond Bounce After Slump Youtube

Oragenics Stock Amex Ogen Quotes And News Summary Benzinga

Ogen Stock Alert The Insider Buying Giving Oragenics Shares Some Oomph Today Nasdaq

Oragenics Stock Amex Ogen Quotes And News Summary Benzinga

Statement Issued By Ogen In Response To Stash Magazine S Drag Article Last Month R Theocs

Oragenics Nyseamerican Ogen Shares Cross Above 200 Day Moving Average Of 0 00 Defense World

Elevated Plasmin Ogen As A Common Risk Factor For Covid 19 Susceptibility Physiological Reviews

Ogen Stock Price And Chart Amex Ogen Tradingview

Ogen Covid 19 Vaccine Candidate Exhibits Protective Immunity In Mice
Oragenics Ogen Message Board Investorshub

Us Stock Market Suffers Worst Start To The Year Since Great Depression